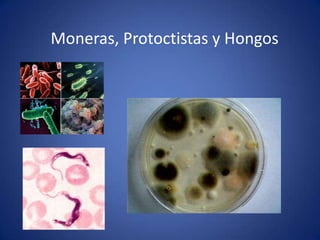

Este documento trata sobre la microbiología. Explica que las bacterias pueden ser autótrofas u heterótrofas dependiendo de su fuente de carbono, y pueden ser fotolitotrofas, quimiolitotrofas, fotoorganotrofas o quimioorganotrofas dependiendo de la energía que utilizan. También describe que las bacterias pueden ser aerobias, anaerobias facultativas, anaerobias aerotolerantes o anaerobias estrictas dependiendo de si requieren o no oxígeno, y que su mecanismo